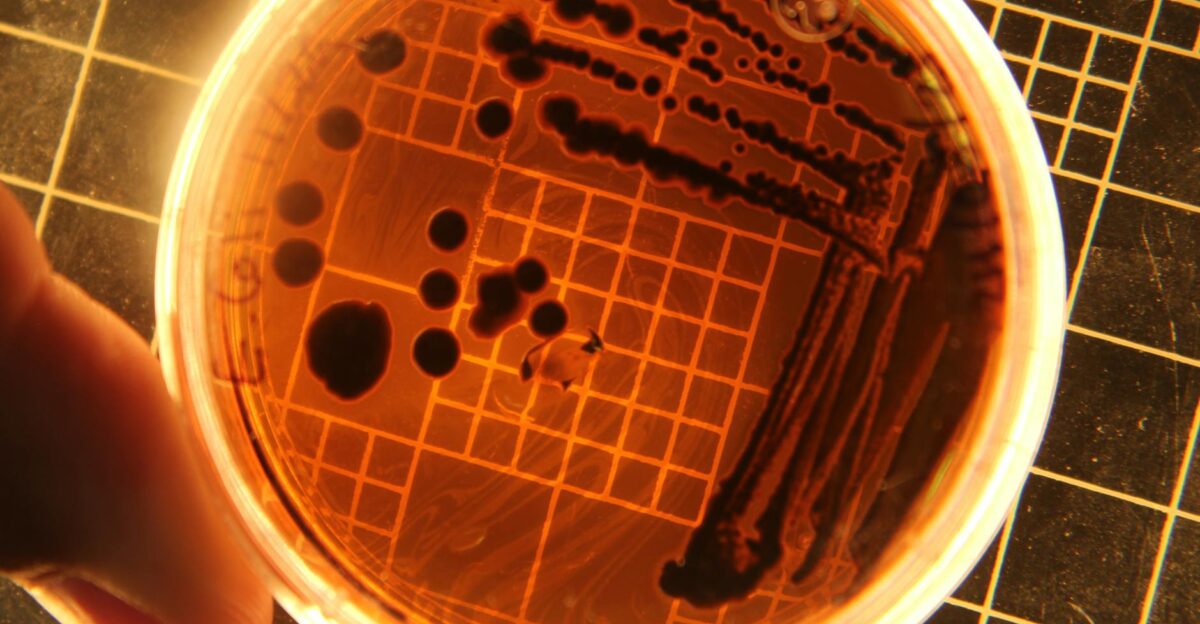

A massive recall is sending shockwaves through school cafeterias nationwide. More than 90,000 pounds of ready-to-eat breakfast burritos have been pulled off shelves after the USDA confirmed that certain products made by M.C.I. Foods, Inc.—including the widely served Los Cabos, El Más Fino, and Midamar brands—may be contaminated with Listeria.
The affected batches, produced between September 17 and October 14, 2025, were distributed to schools serving thousands of students, raising urgent questions for parents, administrators, and food safety officials alike.
Company Behind the Recall

M.C.I. Foods, based in Santa Fe Springs, California, said it discovered the issue after routine testing found Listeria monocytogenes in an egg ingredient supplied by another company.
As soon as the results came in, M.C.I. Foods alerted the USDA’s Food Safety and Inspection Service (FSIS), which labeled the recall as Class I—the agency’s most serious warning, reserved for products that could cause serious illness.
Where the Burritos Went

These burritos weren’t just for store shelves, they were shipped straight to schools across the country, many participating in the USDA’s National School Lunch and Breakfast Programs.
FSIS officials said cafeterias and food service distributors are being told to check their freezers immediately and throw away any affected stock before it reaches students.
Products Under Recall

The recalled items include a range of frozen burritos and wraps under the Los Cabos, El Más Fino, and Midamar labels. Each package carries establishment numbers “EST. 1162A” or “P-5890A” beside the USDA inspection mark.
Those details, the agency said, are the easiest way for schools and vendors to confirm if they’ve got a recalled batch on hand.
Brands Popular in School Meals

These breakfast burritos have long been cafeteria staples: quick to heat, affordable, and reliably filling. For students, they’re a warm, familiar start to the school day—something to look forward to before class.
Now, those same burritos are at the center of a sweeping food safety scare that has left school kitchens scrambling to adjust menus, calm worried parents, and make sure nothing unsafe reaches a child’s tray.
Timeline of Discovery

According to FSIS, the contamination risk surfaced when M.C.I. Foods’ supplier testing turned up a positive result for Listeria in a scrambled egg component.
The good news? It was caught before anyone got sick. The agency said no confirmed illnesses have been linked to the recalled products so far, but investigations are ongoing.
What Listeria Is

Listeria monocytogenes is a stubborn bacteria that causes listeriosis—a potentially dangerous infection. The CDC says it’s particularly harmful for pregnant women, older adults, and anyone with a weakened immune system.
Symptoms can start mild—fever, chills, stomach pain—but in serious cases, it can spread to the bloodstream or brain.
Risks to Pregnant Women

For pregnant women, even a small exposure can be devastating. The CDC warns that Listeria infections during pregnancy can lead to miscarriage, stillbirth, or premature delivery. FSIS officials echoed that concern, reminding consumers that ready-to-eat foods can carry hidden risks if contamination slips through production lines.
No Illnesses Reported So Far

So far, there’s been a sigh of relief—no illnesses have been reported, according to USDA officials. But experts warn that with Listeria, the danger can hide in plain sight. Symptoms often take up to 70 days to appear, meaning the story isn’t over yet.
Health authorities are urging schools and food suppliers to stay vigilant, act quickly, and double-check every shipment. For now, classrooms and playgrounds remain unaffected, but behind the scenes, food safety teams are racing to make sure it stays that way.
Recall Class and Urgency
The Class I label attached to this recall isn’t routine—it’s a red flag. It signals real danger, not just precaution. According to the USDA, this classification is reserved for situations where eating the product carries a “reasonable probability” of causing serious illness or even death.
It’s the same high-alert category used for major outbreaks involving E. coli or Salmonella. In other words, this isn’t a distant threat on paper—it’s the kind of warning that stops cafeterias, warehouses, and food distributors in their tracks.
Nationwide School Impact

Parents and school districts are on alert. Several state education departments—from California to Michigan—have already issued notices, directing cafeterias to pull the burritos from menus.
“This is a fast-moving situation,” one district food service director said, noting how recalls like this disrupt tight school meal schedules overnight.
How to Identify the Recalled Items

The USDA’s Food Safety and Inspection Service (FSIS) says to check for lot codes between 80870 and 80992 on packages made during the affected dates. If there’s a match, schools and distributors are being told to act fast—dispose of the burritos safely or return them to suppliers before they ever reach a cafeteria tray.
Federal Response and Oversight

FSIS has activated its recall coordination team to trace every shipment. The agency said it’s working with state food safety departments to make sure contaminated burritos are removed from school and institutional storage.
These teams also oversee proper disposal to prevent any chance of the products being reused or resold.
M.C.I. Foods’ Statement

In a public statement, M.C.I. Foods said it “acted out of an abundance of caution” once the test result came back. The company stressed that no illnesses have been reported and reaffirmed that “food safety is our top priority.”
FSIS officials said they’re monitoring the company’s follow-up actions to ensure all safety measures are in place.
FSIS Consumer Warning

FSIS has urged institutions not to serve or distribute the recalled burritos. Consumers and cafeteria staff are being asked to double-check freezers, clean any surfaces that may have touched the product, and follow standard food safety practices.
The agency also encouraged anyone with health concerns to contact their local health department.
Broader Food Safety Context

This recall follows a string of similar incidents involving pre-packaged school meals over the past year. In early 2025, another recall targeted frozen meat products linked to bacterial contamination.
Food safety advocates say the frequency of recalls has renewed calls for tighter supplier oversight and more transparent ingredient sourcing.
The Role of Routine Testing

Experts point out that this case is actually an example of the system working. Because M.C.I. Foods caught the contamination during preventive testing—before anyone got sick—it likely stopped a much larger outbreak.
“Preventive testing saves lives,” said Dr. Sandra Eskin, USDA Deputy Under Secretary for Food Safety, in a statement earlier this year on related recalls.
How Listeria Survives

Listeria’s resilience makes it particularly troublesome. The CDC explains that it can survive—and even grow—in cold temperatures, meaning contamination can persist in freezers and fridges long after production.
That’s why proper cleaning, storage, and routine inspections are crucial in industrial kitchens and institutional food settings.
Consumer Advice

The USDA advises anyone who might have the recalled burritos to throw them away immediately, then sanitize any surface or container that held the food. Those experiencing flu-like or digestive symptoms after possible exposure should contact a healthcare provider.
“When in doubt, throw it out,” FSIS said in its recall notice.
Public Health Takeaway

The M.C.I. Foods recall is a sobering reminder of how easily a single ingredient can ripple through the national food supply—reaching schools, cafeterias, and homes. With no confirmed illnesses so far, swift action appears to have prevented harm.
This incident highlights a bigger truth: food safety is only as strong as the vigilance behind it.